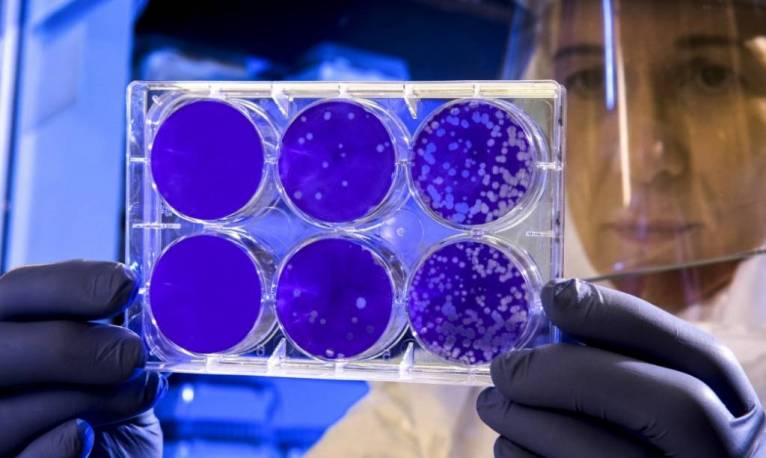
последние новости в Украине останні новини в Україні

Пандемия COVID-19: Украина заинтересована в закупке израильской вакцины
Вакцина от коронавирусной инфекции COVID-19 разрабатывается в Израиле. Украина рассматривает вариант закупки препаратов.
Украинцы могут первыми поучаствовать в исследовании и возможном использовании лекарств от заболевания. Об этом сообщила 14 августа пресс-служба президента Украины.
Президент Владимир Зеленский провел телефонный разговор с главой правительства Израиля Биньямином Нетаньяху. Стороны детально обсудили меры, принимаемые для борьбы с пандемией.
Руководитель государства проинформировал представителя другой страны, что на территории нашего государства зафиксирован очередной антирекорд заболеваемости. Адаптивный карантин не во всех областях демонстрирует результат. Президент также отметил заинтересованность и изучении вопроса украинской стороной по закупке вакцины для своих граждан.
Украина может присоединиться к разработке препарата. Насколько эффективна вакцина, пока неизвестно. В Минздраве для профилактики коронавируса рассчитывают получить для граждан около 8 миллион доз вакцин.
Ранее ASPI news сообщало, что в волынском селе зафиксирована вспышка коронавирусной инфекции COVID-19. Стало также известно, что на территории столицы могут ввести карантинные мероприятия.
По теме
Вокруг пептида FOXO4-DRI в последние годы возник настоящий ажиотаж в сфере anti-age медицины и биохакинга. Ему приписывают способность воздействовать на «стареющие» клетки организма и потенциально замедлять процессы старения. Однако научное сообщество до сих пор относится к подобным разработкам с большой осторожностью.
День влюбленных — это не только повод сказать «люблю», но и подарить эмоции, которые запомнятся надолго. Если вы ищете приятный и действительно ценный подарок для любимого человека, студия массажа Кайф в Одессе предлагает идеальное решение — массаж для двоих.
Сегодня Одесса подверглась массированному удару БПЛА рф. Частично разрушен жилой дом, пострадали 22 человека, повреждена инфраструктура — дома, детский сад, магазины и строительная площадка. Спасательные службы работают на местах, оказывая помощь пострадавшим и ликвидируя последствия удара.
Полномасштабная война стала для украинского бизнеса не только экономическим вызовом, но и проверкой на выносливость, ответственность и человечность.
Mitochondria are the power stations of our cells. Their work determines the level of energy, the rate of metabolism, and even the body's ability to resist diseases. When they work worse, the whole body suffers: fatigue appears, fat accumulates, and chronic diseases develop.
Митохондрии — энергетические станции наших клеток. От их работы зависит уровень энергии, скорость обмена веществ и даже способность организма противостоять заболеваниям. Когда они начинают функционировать хуже, страдает весь организм: появляется усталость, накапливается жир, развиваются хронические болезни.
Many patients undergoing modern weight loss therapy are faced with a situation where the syringe contains more milligrams of the drug than is required for their individual dose. How to calculate your dose correctly - explains endocrinologist and nutritionist Olena Davydenko.
Многие пациенты, проходящие современную терапию для похудения, сталкиваются с ситуацией, когда шприц содержит больше миллиграммов препарата, чем требуется для их индивидуальной дозы. Как правильно рассчитать дозировку — объясняет врач-эндокринолог и нутрициолог Елена Давиденко.
Recently, social media has been actively discussing the latest weight loss drugs that have not yet been approved, but are already showing impressive results in studies. One such drug is retatrutide, an experimental molecule that, according to preliminary data, provides record weight loss. In some patients, the reduction reached more than 24–30% in 11 months of treatment.
В последнее время в социальных сетях активно обсуждают новейшие препараты для снижения веса, которые пока не одобрены, но уже демонстрируют впечатляющие результаты в исследованиях. Один из таких средств — ретатрутид, экспериментальная молекула, которая, по предварительным данным, обеспечивает рекордное снижение массы тела. У некоторых пациентов снижение веса достигало 24–30% за 11 месяцев лечения.
Новости «Здоровье»
Вокруг пептида FOXO4-DRI в последние годы возник настоящий ажиотаж в сфере anti-age медицины и биохакинга. Ему приписывают способность воздействовать на «стареющие» клетки организма и потенциально замедлять процессы старения. Однако научное сообщество до сих пор относится к подобным разработкам с большой осторожностью.
День влюбленных — это не только повод сказать «люблю», но и подарить эмоции, которые запомнятся надолго. Если вы ищете приятный и действительно ценный подарок для любимого человека, студия массажа Кайф в Одессе предлагает идеальное решение — массаж для двоих.
Сегодня Одесса подверглась массированному удару БПЛА рф. Частично разрушен жилой дом, пострадали 22 человека, повреждена инфраструктура — дома, детский сад, магазины и строительная площадка. Спасательные службы работают на местах, оказывая помощь пострадавшим и ликвидируя последствия удара.
Полномасштабная война стала для украинского бизнеса не только экономическим вызовом, но и проверкой на выносливость, ответственность и человечность.













